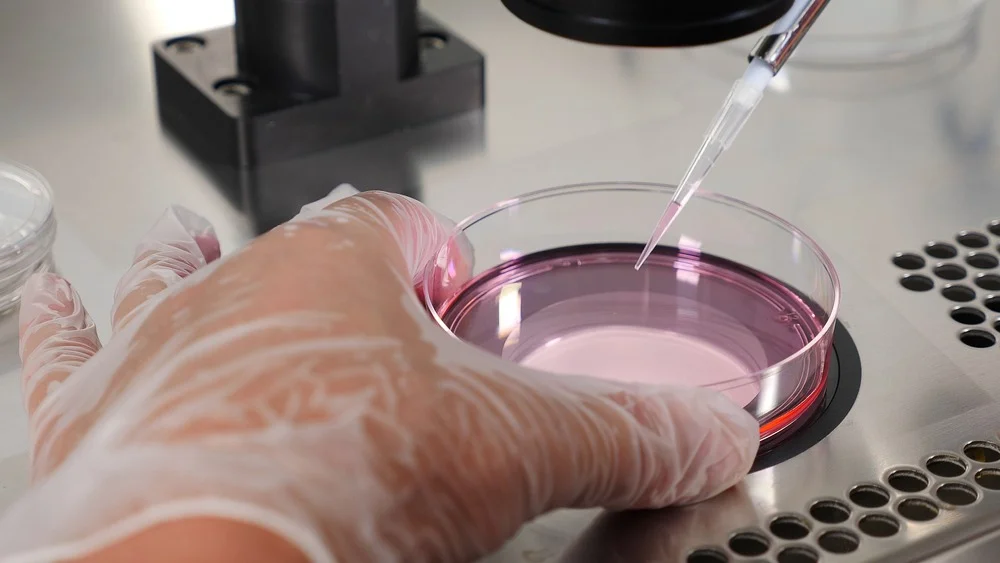

Thụ tinh trong ống nghiệm và những điều cần biết

Chuyên gia viết bài: TS.BS. Ngô Thị Yên
Ủy viên thường vụ Hội Kế hoạch hóa Gia đình Việt Nam / Nguyên Trưởng khoa Kế hoạch hóa gia đình, Bệnh viện Từ Dũ TPHCM
Ngày cập nhật: 26/4/2024
Mục lục
- Có những loại viên uống tránh thai nào?
- Sự khác biệt giữa các loại viên uống tránh thai?
- Làm thế nào để chọn loại viên uống tránh thai phù hợp?
- Viên uống tránh thai có làm tăng cân không?
- Viên uống tránh thai có giúp giảm mụn không?
- Viên uống tránh thai nào giúp giảm đau bụng kinh?
- Có cần kiểm tra định kỳ khi đang sử dụng thuốc tránh thai không?
- Sử dụng thuốc tránh thai có ảnh hưởng đến ham muốn tình dục không?
- Có thể ngừng uống thuốc tránh thai bất cứ lúc nào hay không?
- Viên uống tránh thai có tác dụng phụ gì không?
1. Thụ tinh trong ống nghiệm là gì?
Thụ tinh trong ống nghiệm (In vitro fertilization – IVF) là một kỹ thuật hỗ trợ sinh sản, trong đó trứng (noãn) được thụ tinh với tinh trùng trong ống nghiệm để tạo ra phôi, phôi được nuôi cấy tiếp thêm 2-5 ngày trong tủ nuôi cấy (môi trường tương tự như trong tử cung), và sau đó được chuyển vào buồng tử cung của người phụ nữ.

2. Những ai nên thực hiện IVF?
Một cặp vợ chồng vô sinh có thể được điều trị bằng nhiều phương pháp khác nhau như: bơm tinh trùng vào buồng tử cung (IUI), phẫu thuật nội soi can thiệp…., trong đó thụ tinh trong ống nghiệm gần như là phương pháp cuối cùng được chỉ định cho các cặp vợ chồng vô sinh vì các nguyên nhân sau:
- Vô sinh do tắc vòi trứng, đây có thể xem là chỉ định tuyệt đối cho trường hợp vô sinh do tắc vòi tử cung. Tắc vòi tử cung có thể phẫu thuật nội soi tạo hình (với chi phí thấp hơn IVF) tuy nhiên tỷ lệ thành công của phương pháp này thường thấp và nếu phẫu thuật thất bại thì cặp vợ chồng vẫn cần phải chuyển sang điều trị bằng phương pháp thụ tinh trong ống nghiệm, vô hình chung kéo dài thời gian từ khi điều trị cho đến khi có thai.
- Các trường hợp người phụ nữ lớn tuổi, giảm dự trữ buồng trứng.
- Lạc nội mạc tử cung nặng, đặc biệt là các trường hợp lạc nội mạc tử cung tại buồng trứng cần thiết điều trị thụ tinh trong ống nghiệm vì làm giảm số lượng và chất lượng trứng.

- Các trường hợp buồng trứng đa nang cũng có thể cân nhắc điều trị bằng IVF.
- Các trường hợp vô sinh do nam giới không có tinh trùng hoặc tinh trùng yếu, ít, bất thường nặng cần được chỉ định điều trị thụ tinh trong ống nghiệm. Với mẫu tinh trùng yếu, ít hoặc tinh trùng lấy từ mào tinh, tinh hoàn sẽ không thể sử dụng để bơm trực tiếp vào buồng tử cung được mà sẽ được tiêm trực tiếp vào bào tương noãn (ICSI), làm tăng tỷ lệ thụ tinh và tăng tỷ lệ có thai.
- Các trường hợp vô sinh đã điều trị bằng phương pháp bơm tinh trùng vào buồng tử cung nhiều lần không kết quả (trung bình 4 lần).
3. Tỷ lệ thành công khi thực hiện IVF là bao nhiêu?
Có nhiều tiêu chí khác nhau xác định tỷ lệ thành công như tỷ lệ xét nghiệm hCG dương tính, có thai sau chuyển phôi, nhưng hiện nay người ta xác định, thành công của phương pháp IVF là người phụ nữ sinh con sống, vì kể cả sau chuyển phôi có thai cho đến khi sinh con cũng còn rất nhiều rủi ro như thai chết lưu, sinh non…v.v.
Tỷ lệ thành công phụ thuộc vào rất nhiều yếu tố khác nhau, trong đó độ tuổi của người phụ nữ đóng vai trò khá quan trọng. Ở độ tuổi dưới 35 tỷ lệ thành công có thể lên tới 50-70% nhưng nếu sau 40 tuổi, tỷ lệ này giảm còn 30-35%.

Nguyên nhân vô sinh cũng ảnh hưởng đến tỷ lệ có thai như giảm dự trữ buồng trứng, lạc nội mạc tử cung hoặc vô sinh do nam giới là những nguyên nhân làm giảm tỷ lệ có thai so với nguyên nhân tắc vòi trứng, hay vô sinh không rõ nguyên nhân.
4. Cần chuẩn bị gì trước khi thực hiện IVF?
Trước khi bắt đầu chu kỳ IVF, các cặp vợ chồng sẽ được khám và làm các xét nghiệm tìm nguyên nhân:
- Tư vấn về quy trình thực hiện IVF.
- Đánh giá tử cung, xét nghiệm tế bào cổ tử cung và chụp quang tuyến vú (nếu trên bệnh nhân trên 40 tuổi).
- Xét nghiệm đánh giá dự trữ buồng trứng.
- Xét nghiệm tinh dịch đồ.
- Sàng lọc các bệnh lây truyền qua đường tình dục và các bệnh truyền nhiễm khác.
- Xét nghiệm đánh giá toàn thể để chuẩn bị cho thủ thuật chọc hút trứng dưới gây mê.
- Một số các xét nghiệm chuyên sâu như nhiễm sắc thể hai vợ chồng, sàng lọc một số bất thường bẩm sinh, tan máu bẩm sinh…
- Hoàn thành các thủ tục hành chính theo quy định.

5. Quy trình thực hiện như thế nào?
Kích thích buồng trứng
Kích thích buồng trứng có thể xem là bước quan trọng nhất, nhằm tạo ra số lượng trứng vừa đủ. Trong mỗi chu kỳ tự nhiên ở người phụ nữ khỏe mạnh trong độ tuổi sinh sản, một số nang noãn sẽ được chiêu mộ và có một đến hai noãn trưởng thành và phóng noãn, các nang noãn còn lại sẽ bị thoái hoá.
Trong chu kỳ IVF, bệnh nhân sẽ được tiêm hormon kích thích nang noãn (FSH) hàng ngày với mục đích ngăn ngừa các nang noãn thoái hóa, từ đó giúp cho các nang phát triển đồng thời, thay vì chỉ có một nang trưởng thành thì sau khi kích thích có nhiều nang noãn phát triển. Liều hormon sử dụng phụ thuộc vào dự trữ và đáp ứng buồng trứng của từng bệnh nhân được đánh giá dựa vào nồng độ AMH và đếm số nang thứ cấp. Số nang noãn phát triển cho đến khi chọc hút thường không vượt quá số nang thứ cấp vào đầu chu kỳ kinh.
- Trong quá trình kích thích buồng trứng cần theo dõi sự phát triển nang noãn bằng siêu âm qua đường âm đạo: cần thiết đếm và đo kích thước của tất cả các nang noãn phát triển, thông thường chỉ có các nang trên 12 mm mới có thể chọc hút được noãn. Thường thời gian tiêm thuốc trung bình là 10 ngày. Người bệnh có thể tự tiêm thuốc kích thích buồng trứng tại nhà sau khi được các nhân viên y tế hướng dẫn. Cần lưu ý thuốc được bảo quản ở nhiệt độ tủ lạnh để không giảm tác dụng.
- Tiêm thuốc trưởng thành noãn: khi siêu âm theo dõi nang noãn, đủ điều kiện sẽ được tiêm trưởng thành noãn và sau mũi tiêm này trung bình 34 đến 36 giờ sẽ được chọc hút noãn. Mũi tiêm trưởng thành noãn rất quan trọng, không được phép sai sót vì ảnh hưởng đến số lượng noãn và chất lượng noãn khi chọc hút do vậy người bệnh cần tiêm tại cơ sở y tế, hoặc nếu tự tiêm tại nhà thì phải đảm bảo tự tin về mặt kỹ thuật. Nếu có bât cứ sai sót nào cần thông báo cho bác sỹ ngay.
Chọc hút trứng
Vào ngày chọc hút trứng, bệnh nhân cần nhịn ăn để gây mê. Bác sĩ sẽ chọc hút noãn dưới hướng dẫn siêu âm đường âm đạo và chuyển dịch chọc hút được vào trong Labo để các chuyên viên phôi học tìm noãn trong dịch nang. Thực chất trong dịch nang chọc hút ra có chứa các khối COC (trong đó có cả noãn và tế bào hạt bao quanh noãn), sau đó noãn sẽ được tác ra từ khối COC này và trong số noãn tách ra sẽ có các noãn trưởng thành (M2), noãn non (M1 và GV) hoặc noãn thoái hóa, chỉ có các noãn trưởng thành mới có thể cho thụ tinh được. Tất cả quá trình chọc hút trứng mất khoảng từ 10 đến 15 phút.
Vào ngày chọc hút noãn chồng phải lấy được tinh trùng để cho tinh trùng thụ tinh với noãn. Nếu không lấy được tinh trùng sẽ phải trữ lạnh noãn do vậy người chồng cần thông báo với bác sỹ nếu khó lấy mẫu, khi đo bác sỹ sẽ cho lấy mẫu trữ lạnh trước đề phòng vào ngày chọc hút noãn người chồng không lấy được tinh trùng.
Thụ tinh
Sau chọc hút noãn khoảng 3 giờ, noãn trưởng thành sẽ được cho thụ tinh hoặc bằng phương pháp thông thường hoặc tiêm tinh trùng vào bào tương noãn (ICSI), hiện nay đa số các trường hợp được cho tinh trùng thụ tinh với noãn bằng phương pháp ICSI. Khoảng 18 giờ sau khi cho thụ tinh sẽ đánh giá xem noãn có thụ tinh hay không. Thông thường sẽ khoảng 90% số noãn sẽ thụ tinh, tùy thuộc vào chất lượng noãn, chất lượng tinh trùng và cả kỹ thuật của chuyên viên phôi học.
Theo dõi sự phát triển của phôi sau thụ tinh
Phôi sẽ phát triển trong tủ nuôi cấy qua các ngày 2-5 ngày, qua mỗi giai đoạn phát triển của phôi sẽ được các chuyên viên phôi học đánh giá và ghi nhận hàng ngày (thông thường ở thời điểm ngày 2, 3 và 5. Phôi có thể được chuyển phôi tươi hoặc đông phôi ở các giai đoạn này. Tỷ lệ phôi phát triển từ khi thụ tinh cho đến giai đoạn ngày 5 chỉ khoảng 50 đến 65%.
Chuyển phôi tươi
Phôi tươi được chuyển ngày 2, ngày 3 hoặc ngày 5 tùy vào đặc điểm của từng bệnh nhân cũng như của từng trung tâm. Sau chuyển phôi sẽ được hỗ trợ hoàng thể bằng hormon progesterone đường uống hoặc đường âm đạo. Số phôi còn lại sẽ được trữ đông bằng phương pháp thủy tinh hóa, là một phương pháp bảo quản phôi tốt nhất hiện nay với tỷ lệ phôi sống sau rã đông cao, chất lượng sau rã đông không giảm.

Chuyển phôi trữ đông
Hiện nay xu hướng chuyển phôi trữ đông ngày càng tăng lên so với chuyển phôi tươi vì nhiều lý do như giảm nguy cơ quá kích buồng trứng, niêm mạc tử cung không thuận lợi…chuyển phôi đông lạnh có thể sớm nhất sau 1 chu kỳ. Niêm mạc tử cung được chuẩn bị trước khi chuyển phôi đông lạnh bằng chu kì tự nhiên hoặc dùng hormon nhân tạo loại estrogen (đường uống, bôi da) và vẫn được hỗ trợ pha hoàng thể bằng progesterone tương tự như chuyển phôi tươi. Số phôi chuyển trong một chu kì thông thường giới hạn tối đa là 2 phôi. Nếu phôi ngày 5 và chất lượng tốt thì nên chuyển 1 phôi hạn chế đa thai. Thủ thuật chuyển phôi thường kéo dài trung bình 10 phút.
Theo dõi thai kỳ
Khoảng 10 ngày sau chuyển phôi sẽ được xét nghiệm định lượng βhCG trong máu. Nếu nồng độ βhCG trên 25 đv/l xác định có thai, tuy nhiên nồng độ hCG thấp thường liên quan đến nguy cơ thai sinh hóa, bị chết lưu hoặc thai ngoài tử cung.
Bệnh nhân không cần định lượng hCG nhiều lần để tiên lượng tình trạng thai vì ít đem lại lợi ích. Khoảng 20 ngày sau chuyển phôi là có thể quan sát được túi thai trong tử cung và sau 28 ngày sau chuyển có thể quan sát được âm vang thai với kích thước khoảng vài mm kèm theo hoạt động tim thai. Bệnh nhân sẽ được bác sỹ hẹn theo dõi định kì cho đến 12 tuần. Các thuốc nội tiết sẽ được điều chỉnh sau mỗi lần thăm khám. Nhìn chung sau 12 tuần sẽ ngừng hết các thuốc nội tiết.

6. Sau khi thực hiện IVF cần lưu ý gì?
Sau chọc hút noãn bệnh nhân có thể ra về trong ngày, thực hiện thuốc theo y lệnh của bác sỹ bao gồm kháng sinh dự phòng nhiễm trùng sau thủ thuật chọc hút trứng và thuốc hỗ trợ hoàng thể nếu có chuyển phôi tươi. Cần hạn chế di chuyển nhanh như chạy nhảy vì buồng trứng còn to nên có nguy cơ bị xoắn.
Sau khi chuyển phôi bệnh nhân có thể lựa chọn tự đi về luôn hoặc nằm nghỉ 30 phút trước khi ra về sau đó trở lại sinh hoạt và làm việc bình thường như hàng ngày, tuân thủ theo hướng dẫn của thầy thuốc và dùng thuốc đúng theo chỉ định. Việc nghỉ ngơi cũng không làm tăng tỷ lệ có thai so với không nghỉ ngơi. Sau chuyển phôi 10 ngày có thể xét nghiệm beta-hCG để xác định có thai, và nếu có thai sẽ tiếp tục dùng thuốc hỗ trợ hoàng thể cho đến khi thai được 10 -12 tuần, tùy thuộc vào quyết định của bác sỹ.

7. Có nên sinh mổ khi thực hiện IVF?
Hiện nay các trường hợp thai sau IVF thường được các bệnh nhân lựa chọn mổ lấy thai vì lý do con quý hiếm, tuy nhiên xét về bằng chứng khoa học thì thai sau IVF không nhất thiết phải mổ lấy thai vì hoàn toàn có thể sinh đường âm đạo được. Chỉ mổ các trường hợp có chỉ định thật sự như thai to, tư thế thai bất thường trong buồng tử cung hoặc các trường hợp bệnh lý trong thời kỳ mang thai.
Các chỉ định mổ trong trường hợp thai IVF là:
- Thai to, ngôi ngược, thai suy.
- Tiền sản giật, rau tiền đạo.
- Có vết mổ lấy thai cũ.
- Có khối u trong tiểu khung như u nang buồng trứng, u xơ tử cung.
- Ối vỡ sớm…
8. Thai IVF hay ra máu có sao không?
Theo thống kê, khoảng 25% phụ nữ sẽ bị ra máu trong ba tháng đầu của thai kỳ và thường phổ biến hơn ở các trường hợp thai IVF. Lý do ra máu tăng có thể liên quan đến thiếu hormone, nên bệnh nhân phải duy trì theo đúng chỉ định của bác sỹ. Thông thường khi ra máu âm đạo bác sỹ thường tăng liều progesterone hoặc bổ sung thêm đường tiêm.
Trong trường hợp ra máu nhiều bệnh nhân cần đến bệnh viện ngay để được thăm khám và nhập viện theo dõi. Phần lớn các trường hợp máu sẽ tự cầm và thai phát triển bình thường, tuy nhiên cũng có một tỷ lệ nhỏ khoảng 6% các trường hợp thai bị ngừng phát triển.
9. Có cần kiêng quan hệ trước khi làm IVF?

Trong giai đoạn kích thích buồng trứng
Trong giai đoạn kích thích buồng trứng vợ chồng có thể quan hệ tình dục, tuy nhiên nên hạn chế vì buồng trứng to, có nguy cơ bị xoắn buồng trứng hoặc đau bụng. Nam giới cần kiêng xuất tinh ít nhất 48 giờ trước khi lấy tinh trùng để đảm bảo có đủ tinh trùng trong mẫu tinh dịch, tuy nhiên, kiêng lâu hơn 5 – 7 ngày có thể nhiều tinh trùng bị chết.
Sau khi chuyển phôi
Không có khuyến cáo kiêng quan hệ tình dục sau chuyển phôi, thậm chí một số nghiên cứu cho thấy việc quan hệ tình dục sau chuyển phôi làm tăng tỷ lệ có thai. Mặc dù vậy đa số các cặp vợ chồng đều tránh quan hệ tình dục trong thời gian này, dù bác sỹ có khuyến cáo. Sau khi thực hiện xét nghiệm có thai cặp vợ chồng có thể quan hệ tình dục tuy vậy cần đảm bảo an toàn cho thai vì cũng có nguy cơ dọa sảy thai.